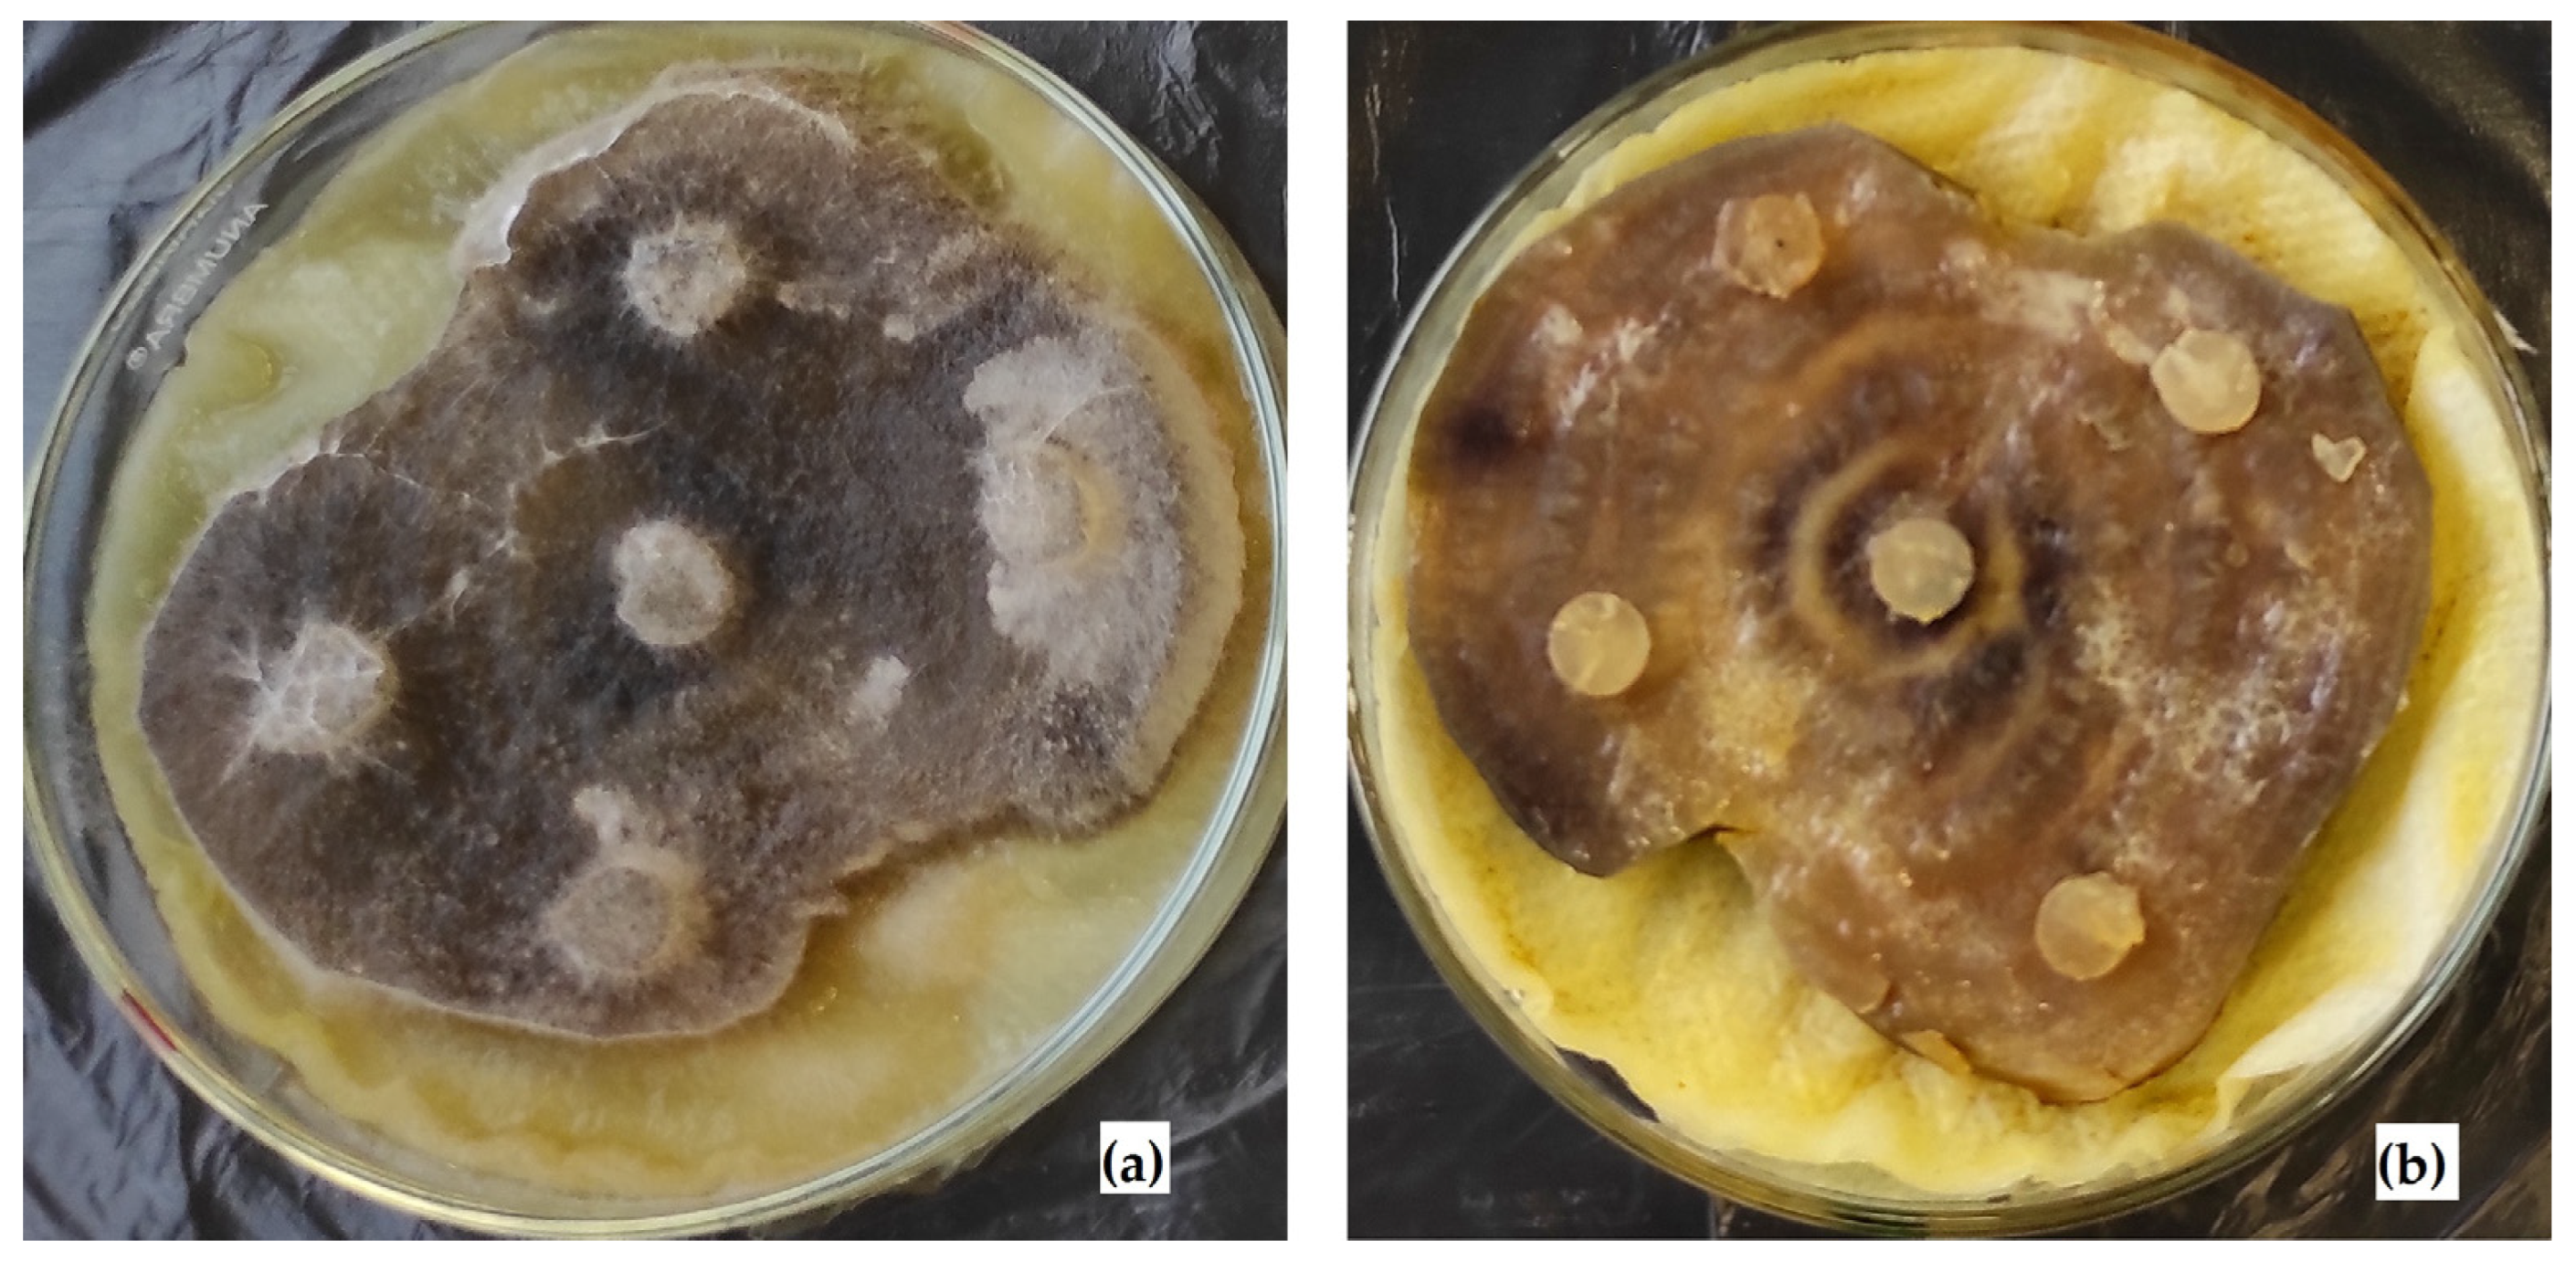
Applsci 13 06362 g005
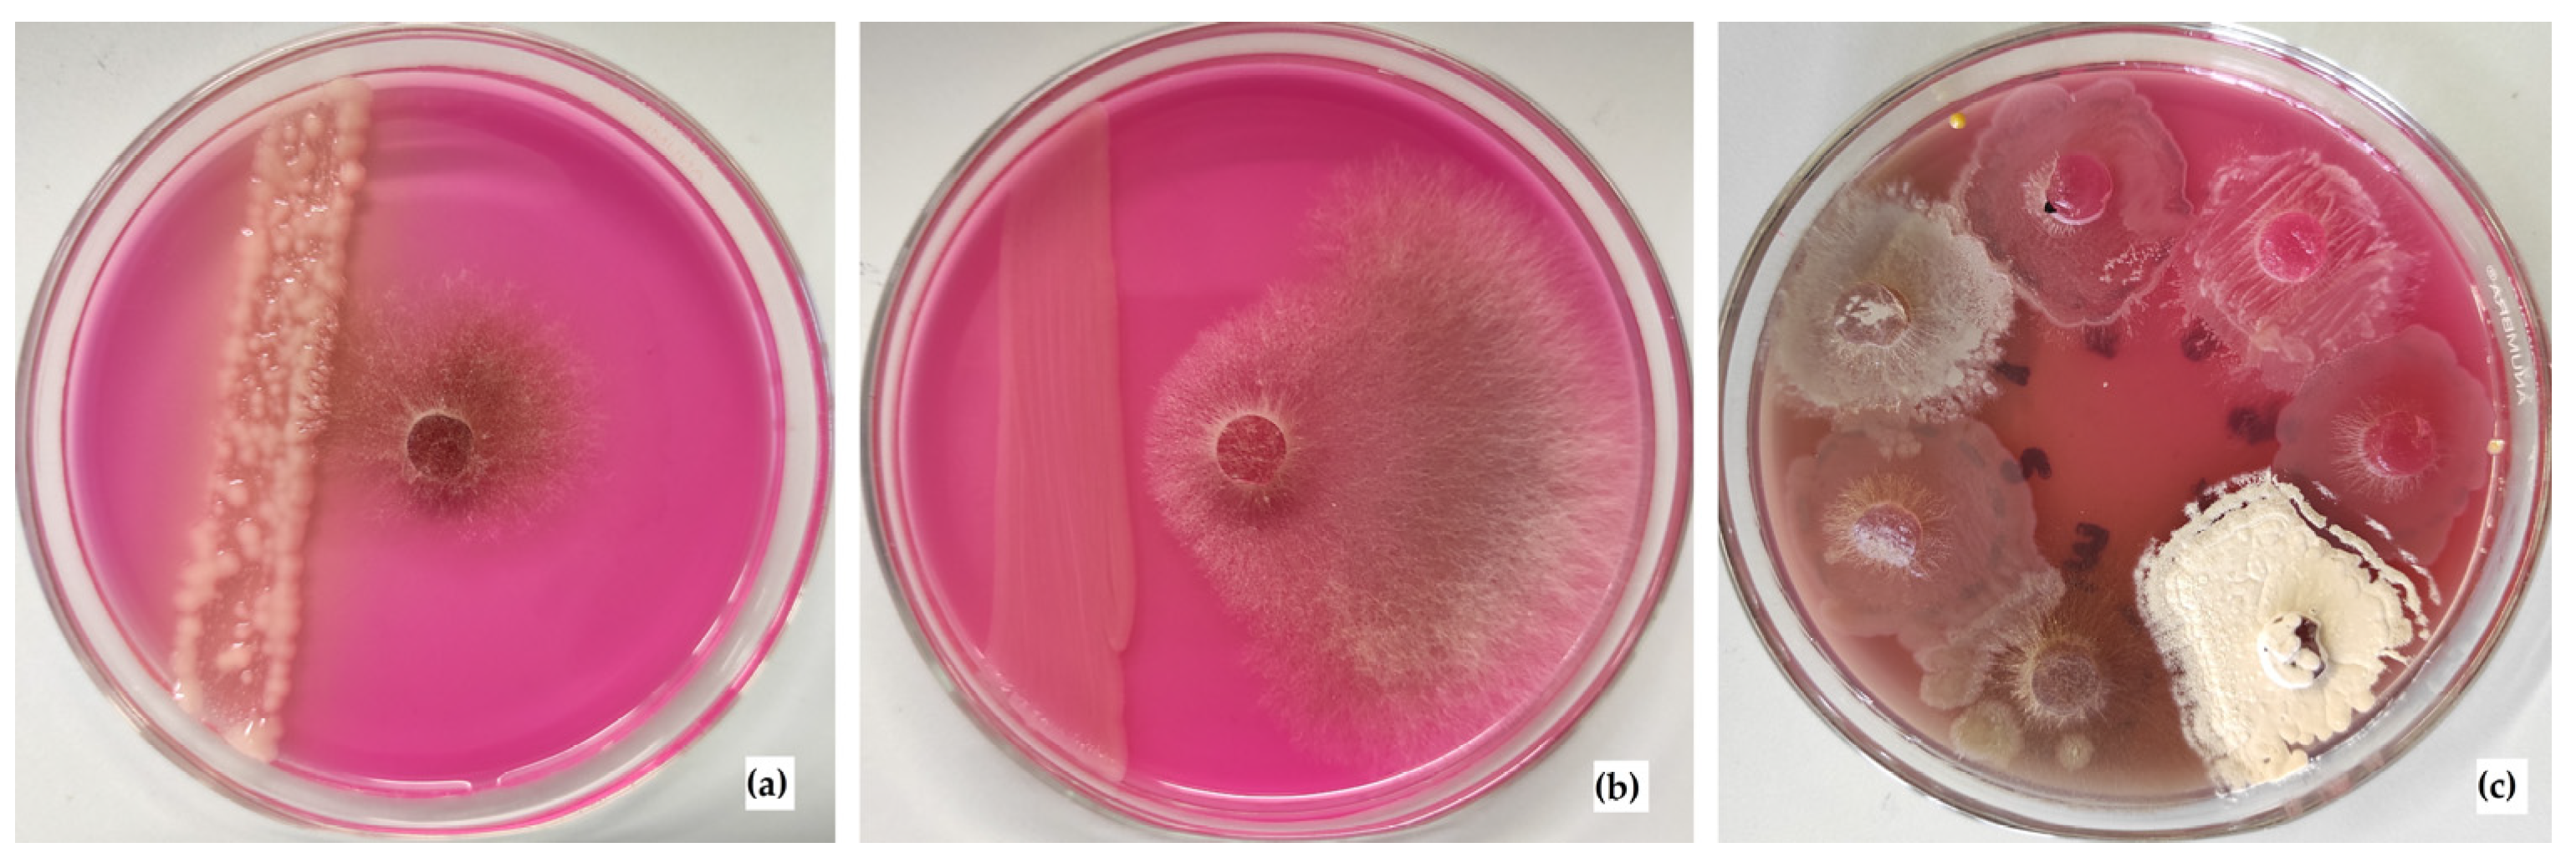
Applsci 13 06362 g006

Abstract
Sugar beet (Beta vulgaris L.) is a valuable sugar-providing crop accounting for around 25% of global white sugar production. It is an integral part of the food industry. Several factors cause a decrease in the yield of this food crop. The infection of phytopathogenic fungi is one of the most hazardous. Though several methods to control Rhizoctonia solani have been developed, the problem is still not solved. Thus, the goal of this work was to investigate the effect of abiotic factors (pH, Eh, presence or absence of O2) and biotic ones (microbial community) on the fungal pathogen R. solani AG 2-2IIIB for its control and sugar beet protection. Microbiological methods were used to conduct the research. Thermodynamic calculations were applied to determine the conditions necessary for suppression of R. solani AG 2-2IIIB. As a result, a comparison of the effect of abiotic and biotic mediated factors on the efficiency of the growth of Rhizoctonia solani AG 2-2IIIB was carried out. Obtained data showed the following: mainly the abiotic factors provided via chemical buffers or removal of oxygen caused the inhibition of R. solani; the values of 5.5 ≤ pH ≤ 8.5, Eh ≤ −200 mV, and oxygen absence inhibited its growth. The maintenance of these factors via microbial communities enhanced the suppressive effect, bringing about the death of mycelium. The study of microbial strains revealed the inhibitory effect of microbial metabolites and provided more effective control of Rhizoctonia solani AG 2-2IIIB.
1. Introduction
Human population growth requires an increase in crop yields to increase the amount of food produced. However, the productivity of fields depends on many factors: climate conditions, application of fertilizers, pathogens, etc. [1].
Fungi play an important role in soil: they decompose organics, transport nutrients, and interact with plants and the microbiome [2]. However, fungal pathogens are among the most hazardous to crops. They cause disease in different crop species and contribute to harvest loss on a large scale. Rhizoctonia solani is one of the most widespread pathogens, infecting more than 200 species of valuable agricultural crops [3]: sugar beets [4], potatoes [5], rice plants [1,3], maize, cotton [3], etc. For example, R. solani threatens to destroy up to 45% of the rice crop worldwide because of a serious rice sheath blight disease [3]. In the period from 2003 to 2015, about 19% of potato yields were destroyed by R. solani in the Castilla y León region (Spain’s largest autonomous region) [5]. In general, about 5–10% of the sugar beet area of Europe and the United States is affected or threatened by this pathogen [6]. The infection of sugar beets by R. solani can result in a loss of up to 60% of yield. Moreover, stored sugar beets can be destroyed by it [7]. About 5% (70,000 ha) of the sugar beet cropping area in Europe is affected by R. solani [8]. Sugar beet is essential for agriculture and industry, since it is one of only two plants providing sucrose [7]. It covers about 35% of the global white sugar harvest [9]. Therefore, the project of reducing the impact of R. solani and inhibiting its growth is of great interest to those wishing to prevent the loss of crop yields.
Different strategies have been developed to fight against this plant pathogen. The cultivation of sugar beet varieties resistant to R. solani is one of the most important among them [10,11]. However, only partially resistant varieties are known. They require additional control and provide lower yields [8]. Suppression of the pathogen in soil is another strategy. Formerly, the application of fungicides was a widespread method. However, their long-term use caused the formation of resistance, as well as pollution of the environment [1,12]. The appearance of new strains frequently caused a loss in the efficiency of existing fungicides [13]. Therefore, other approaches are of great interest. Nowadays, the method of suppression of R. solani growth by microorganisms or by some organic compounds is popular [1,5,8]. For example, Trichoderma harzianum was shown to be antagonistic to R. solani via growth on the mycelium, penetration into cells, and production of chitinase and β-(1,3)-glucanase [12]. Microbial species Pseudomonas stutzeri was reported to inhibit the growth of R. solani via lipase production for the degradation of fungal cell wall lipids [1]. Bacillus sp. was shown to be a commonly used control agent [14]. The application of different organic amendments was also revealed to be promising. The inhibition of R. solani, together with plant growth promotion, was shown via the application of compost [5]. Chitin and keratin amendments have been shown to suppress pathogenic fungi [8]. Brassica tissues (mustard oilcake) were also reported to inhibit R. solani. The thioglucoside compounds that they contain were hydrolyzed to isothiocyanates, providing fungi suppression [12]. These methods are promising. However, they are often unpredictable, since there is not enough data to regulate and control the process [8,15,16]. The creation of unfavorable growth conditions for R. solani is the general purpose of each one of these methods. However, they approach the problem in a limited way, considering the interaction of certain compounds or biological control agents with R. solani separately. That is their weakness.
Several anastomosis groups of R. solani are involved in sugar beet and potato disease, including AG 1 to AG 5. The isolates belonging to AG 2 and AG 4 were identified as the most frequently occurring in sugar beet production, and AG 3 in potato cultivation [17,18]. Crown and root rot, as well as the damping off of sugar beets, are mostly caused by two intraspecific groups of R. solani: AG 2-2 IIIB and AG 2-2 IV [17,19,20,21]. AG 2-2 IIIB is more virulent to sugar beets than AG 2-2 IV [19]. Both of these are found worldwide, but AG 2-2 IIIB seems to be more common in Europe, especially in the fields where corn and sugar beets are cultivated alternately [22]. In Europe, more than 36,000 ha are affected by R. solani AG 2-2 IIIB each year [23,24]. The productivity of valuable food plants strongly depends on the control of this phytopathogenic agent.
Therefore, the goal of the work was to investigate the effect of abiotic factors (pH, Eh, presence or absence of O2) and biotic ones (microbial community) on the fungal pathogen R. solani AG 2-2IIIB for its control and sugar beet protection.
2. Materials and Methods
2.1. Thermodynamic Background of the Growth Conditions of Rhizoctonia solani AG 2-2IIIB
R. solani AG 2-2IIIB (strain ID 105) culture was obtained from mature sugar beet root and stored on wheat grains at −30 °C. In short, it was grown on a PDA medium (BioMaxima S.A., Lublin, Poland). The strain was identified predominantly based on morphological features, and then with anastomosing tests with testers and ITS1-ITS2 sequence [25]. The ITS1-ITS2 sequence of R. solani ID 105 was deposited in the GeneBank database with the accession number KX810067.
To evaluate the growth conditions of R. solani AG 2-2IIIB, and to have the opportunity to regulate them, the Pourbaix diagrams were used [26,27]. A field of water stability (i.e., the zone where water remains in the liquid state) determined by pH and redox potential (Eh) was built. The effect of pH and Eh on the growth of R. solani AG 2-2IIIB was assessed.
2.2. Factors Studied to Control Rhizoctonia solani AG 2-2IIIB
The following factors were studied to control R. solani AG 2-2IIIB: abiotic (pH, Eh, O2 content created via chemical buffers and air removal via its replacement by argon) and biotic (microbial community of the compost). Their influence on R. solani AG 2-2IIIB was investigated.
2.3. pH Maintenance via Abiotic Factors to Control Rhizoctonia solani AG 2-2IIIB
To cultivate the fungus, peptone broth (BioMaxima S.A., Poland) with yeast extract (BioMaxima S.A., Poland) was used. The medium was prepared in accordance with the instructions of the manufacturer.
To maintain pH of the culture medium, buffer solutions at a concentration of 10 g/L were used (NaH2PO4, Na3PO4, and their mixture). The solution of NaH2PO4 was characterized by pH = 4.43. The buffer Na3PO4 provided pH = 12.1. The mixture of NaH2PO4/Na3PO4 at the ratio 1.6:1 resulted in pH = 7.09. The Na3PO4/NaH2PO4 mixture with the ratio 1.2:1 provided pH = 8.45. The heating during the sterilization of the solutions did not significantly change the pH values. To study the efficiency of the fungus growth, the following values of pH of culture medium were studied: 5.5; 7.0; 8.5. To reach the required pH, the culture medium was mixed with the corresponding buffer solution at the ratio 1:1. In the medium, the solution of NaH2PO4 provided pH = 5.3; the mixture NaH2PO4/Na3PO4 provided pH = 7.0; the mixture Na3PO4/NaH2PO4 provided pH = 8.5. The culture medium without buffers was twice diluted by distilled water and was used as the control for R. solani AG 2-2IIIB growth. The cultivation was conducted in 150 mL flasks where 50 mL of medium was added. The inoculation of R. solani AG 2-2IIIB was carried out via introduction of an agar block with a three-day culture. The block diameter was 7 mm. The cultivation was conducted at 25 °C. The experiment was carried out in five replicates. Growth activity was evaluated via the measurement of the length of mycelium from the agar block to its distal part.
2.4. Eh Maintenance via Abiotic Factors to Control Rhizoctonia solani AG 2-2IIIB
To evaluate the effect of the redox potential of the culture medium and oxygen on the growth of the fungus, the following procedure was carried out. The cultivation of R. solani AG 2-2IIIB was conducted in 150 mL flasks with 50 mL of peptone broth. R. solani AG 2-2IIIB inoculation was carried out via the introduction of the agar block (7 mm in diameter) with the three-day culture. The conditions created for the cultivation are described in Table 1.
Table 1.
Conditions for the growth of Rhizoctonia solani AG 2-2IIIB.
For aerobic conditions, the cultivation was conducted in flasks with cotton stoppers to ensure that air was present. For anoxygenic conditions, the removal of air was ensured via its replacement with inert gas (argon). For this purpose, the flask was purged with argon at a flow rate of 0.5 L/min for 10 min. To create anaerobic low potential conditions, air was replaced by argon, and the solution of Fe(II) citrate (2 mL) was added to create low potential conditions (−200…−180 mV) in the medium.
The stock solution of low potential buffer Fe(II) citrate at the concentration of 20 g/L was prepared as follows. To prepare 100 mL of the solution, 50 mL of distilled water was added to a 200 mL flask, closed with a cotton stopper, and purged with argon at a rate of 0.5 L/min for 10 min. After that, 17.34 g of trisubstituted sodium citrate was added into the flask under a stream of argon. After the dissolution of sodium citrate crystals, 8.66 g of FeSO4 × 5H2O crystals were added to the flask. To obtain pH = 7.0, Na2CO3 was added. The pH value was controlled potentiometrically. To reach the volume of 100 mL of solution, the remaining amount of distilled water was added after the pH adjustment. The resulting mixture was purged with argon for 5 min and hermetically closed with a rubber plug and metal shutter. The solution was sterilized in a boiling water bath for 20 min.
The cultivation was conducted at 25 °C. The experiment was carried out in triplicate. The growth activity was evaluated via the measurement of the length of mycelium from the external edge of the agar block to its distal part.
2.5. Verification of Rhizoctonia solani AG 2-2IIIB Growth after Unfavorable Anoxygenic and Anaerobic Cultivation Conditions
To evaluate whether anoxygenic and anaerobic conditions cause the death of R. solani AG 2-2IIIB, the following procedure was conducted. After 7 days of exposure under such conditions (see Section 2.3), the agar blocks with the fungus that served as the inoculum were transferred to 150 mL flasks with 50 mL of peptone broth. The cultivation was carried out in aerobic conditions at 25 °C. The growth was observed via the measurement of the length of mycelium from the agar block to its distal part.
2.6. Maintenance of Unfavorable Growth Conditions for Rhizoctonia solani AG 2-2IIIB via Biotic Factors
To study the pathway to control R. solani AG 2-2IIIB via biotic factors, a microbial community from compost was used. Plant residues were used for composting. The compost sample was taken from the countryside in Opole region. Before the investigation, it was stored in the refrigerator at +5 °C. The species content of its microbiome was not identified, since there was no need to analyze it. The compost served as the source of microbial community. Though the composition of species in it can differ, their general function is the same: degradation of organic substrate reducing Eh and O2 content in the medium [28,29]. Creation of such conditions is necessary to suppress R. solani AG 2-2IIIB.
To investigate the effect of microbial community on R. solani AG 2-2IIIB, the agar blocks with the fungus were inoculated in aerobic conditions into 150 mL flasks with 50 mL of peptone broth and 1 g of compost. The flasks were hermetically closed with silicon stoppers. The cultivation was carried out for 7 days at 25 °C. The fungus growth was observed via the measurement of the length of the mycelium. The cultivation of R. solani AG 2-2IIIB and microbial community was also conducted in separate flasks under the same conditions. The values of pH and Eh were measured potentiometrically via Elmerton pH/conductivity meter CPC-411, electrode pH EPS-1, and electrode redox ERS-2, respectively.
To confirm the death of mycelium after cultivation, the agar blocks with Rhizoctonia were sequentially transferred from the flasks to peptone agar in Petri plates after each day of cultivation. For this purpose, the agar block was ground in the sterile mortar. The mixture was transferred onto peptone agar and spread over the surface with a Dryhalsky spatula.
To confirm the effect of microbial community on R. solani AG 2-2IIIB, cultivation on a solid substrate imitating the structure of soil was conducted. To model it, glass balls with a diameter of 2 mm were used. Petri plates were used as cultivators. The Petri plates were filled with 3 layers of glass balls and nutrient broth. To create aerobic conditions, glass balls were placed into the bottom of Petri plates that were covered with a lid to provide oxygen access. To create anoxygenic and anaerobic conditions, balls were placed into the lid and covered with the bottom, used upside down. To create anaerobic conditions the solution of Fe(II) citrate (1 mL) was added to peptone broth. The limitation of oxygen access was achieved by filling the gap between the lid and the bottom with a mixture of petroleum jelly and paraffin in a ratio of 1:1 after the inoculation. The separate growth of R. solani AG 2-2IIIB and the microbial community as well as their joint cultivation were studied. The agar blocks (7 mm diameter) with the pre-cultivated Rhizoctonia were placed in the center of the plates and used as the growth control. To study the effect of microbial community, a suspension of compost was prepared. For this, 1 g was diluted in 99 mL of peptone broth. This suspension (0.1 mL) was used to inoculate Petri plates. The cultivation took 7 days at 25 °C. The fungus growth was observed via the measurement of the length of the mycelium from the agar block to its distal part. To indicate the pH and redox potential of the medium in Petri plates, the indicator 0.01% bromothymol blue (BTB) was used. It changes color depending on the conditions: pH > 7—blue, pH = 7—green, 5 < pH < 6—yellow, and pH < 5—bright yellow. As the redox indicator, it turns colorless at Eh ≤ −200 mV (pH = 7.0–7.8). Sodium resazurin solution (0.01%) was also used to control redox potential. At the potential above −50 mV, it is purple. At the potential range of −50 to −100 mV, it is pink, and at less than −100 mV, the colorless form is observed. The solutions of the indicators were added to the media until the color was visually detectable.
R. solani AG 2-2IIIB growth on its natural substrate (sugar beets) was also studied with reference to the effect of microbial community. For this purpose, a sugar beet tuber was sliced with a 5 mm width and 5–7 cm diameter. One slice was placed on filter paper, with one per Petri plate. Petri plates with sugar beets were sterilized in an autoclave at 1.0 atm., 120 °C for 20 min. The inoculation was conducted via the placement of 5 agar blocks with the pre-cultivated R. solani AG 2-2IIIB at an equal distance from each other. The experimental Petri plates contained Rhizoctonia and 5 mL of the suspension of microbial community in sterilized tap water. In the control plates, R. solani AG 2-2IIIB and the microbial community were cultivated separately. The indicators BTB and resazurin sodium salt were used. The length of the grown mycelium was measured. The treatments were conducted in triplicate at 25 °C for 10 days.
2.7. Isolation of the Best Performing Antagonistic Strains against Rhizoctonia solani AG 2-2IIIB
The isolation of strains from microbial community was conducted via the investigation of its effect on R. solani AG 2-2IIIB in 150 mL flasks in peptone broth. After 7 days of cultivation, the aliquot (0.1 mL) of the culture liquid was transferred to nutrient agar and spread on the surface via the spatula. The grown microbial colonies were reisolated 3 times to obtain pure cultures.
2.8. Study of the Antagonistic Properties of the Isolated Strains against Rhizoctonia solani AG 2-2IIIB
The antagonistic properties of the isolated microbial strains were investigated via two methods. The first one provided the placement of the agar block with the pre-cultivated R. solani AG 2-2IIIB in the center of nutrient agar in the Petri plate, with the creation of the stripe of microbial culture in the distal part of the plate. Here, the indirect interaction between the fungus and the strain could be studied. The second method was conducted as follows. The strains were inoculated on nutrient agar at an equal distance from each other, creating a spot with a diameter of 2 cm. The agar blocks with the pre-cultivated R. solani AG 2-2IIIB were placed in the center of each spot. In this way, the direct interaction of the fungus and microorganisms could be observed. Sodium resazurin added to the medium was used as the indicator of metabolic activity.
2.9. Data Analysis
Data analysis was conducted using the statistical platform of Microsoft Excel. Graphs were constructed via OriginLab software, version 8.5.1. Mean values and standard deviations (SDs) were determined with a 95% confidence level. The values were presented as the mean ± SD.
3. Results
3.1. Thermodynamic Background for Control of Rhizoctonia solani AG 2-2IIIB
To develop the approach of effective control of the phytopathogenic fungus Rhizoctonia solani AG 2-2IIIB, a method of thermodynamic prediction was applied to consider the key conditions of the environment that affect its growth. The field of water stability in the coordinates of pH and Eh was studied to highlight the optimal conditions as well as those causing inhibition and death of the fungus. We applied classical Pourbaix diagrams adapted for biological systems [26,30]. In biology, microbiology, and biochemistry, standard potentials (Eo′) are calculated for pH = 7.0 at a one-molar concentration of reacting components and a temperature of 25 °C [31] (Figure 1). Under these conditions, the zone of water stability is in the range of standard redox potentials from Eo′ = −414 mV (lower limit) to Eo′ = +814 mV (upper limit). Water has the properties of a binary redox buffer. At the values of redox potential Eo′ > +814 mV, water oxygen (O2−) acts as a reducing agent and is oxidized to molecular oxygen O2:
2H2O = O2 + 4H+ (reaction No. 1).
Figure 1.
Thermodynamic calculations of zones compatible and incompatible with the life of Rhizoctonia solani AG 2-2IIIB: upper (a) and lower (b) limits of water stability in the Eo′ range from +814 mV to −414 mV; c—separation of aerobic and anoxygenic zones. Upper limit of water stability is described by reaction 2H2O = O2 + 4H+ and equation Eo= 1.228–0.0591 × pH—0.0295 × lgPH2, where PH2 is partial pressure of hydrogen. Lower limit is described by reaction 2H+ = 2e = H2 and equation Eo= 0.000–0.0591 × pH × lgPH2.
Clearly, the redox potential of water returns to its original value, i.e., to Eo′ = +814 mV. At the values of redox potential Eo′ < −414 mV proton (H+) serves as the oxidizer. If the redox potential of the solution is less than −414 mV, two protons (2H+) will be reduced to H2 and the potential will return to initial value Eo′ = −414 mV:
2H+ + 2e = H2 (reaction No. 2).
That is why the whole diversity of bioenergetic reactions are possible only within the zone of the thermodynamic stability of water, i.e., in the Eo′ range from −414 to +814 mV.
Microorganisms efficiently use redox reactions in a wide range of water stability potentials to obtain energy. Thus, microorganisms use reaction No. 1 for both aerobic metabolism (Corganic + 2O2 + 4H+ = CO2 + 2H2O) and photosynthesis (CO2 + 2H2O + hŋ = Corganic + 2O2 + 4H+). Reaction No. 2 is used by microorganisms, for example, for hydrogen fermentation (C6H12O6 + 4H+ = 2H2 + CO2 + CH3COOH) and methanogenesis (4H2 + CO2 = CH4 + 2H2O).
The application of thermodynamic prediction to suppress the growth of microorganisms, in fact, is the calculation of zones that are incompatible with the life of this organism depending on pH and Eh. To achieve the suppression or death of the investigated strain, it is necessary to create corresponding conditions using physicochemical factors, biological factors (microbiome, etc.) or combination of them. Therefore, we calculated the thermodynamic conditions taking into account the physiological characteristics of Rhizoctonia solani AG 2-2IIIB (Figure 1).
R. solani AG 2-2IIIB belongs to obligate aerobic microorganisms with optimal pH values varied between 4.0 and 8.0. The considerations of its metabolism in relation to aerobic conditions, expressed in the pH-Eh dependence, are as follows. The aerobic zone is in the pH range from 0.0 to 13.0 and covers the area of 600 mV in the range of Eo′ from +200 mV (point No. 12) to +814 mV (point No. 15). However, taking into account the fact that air content is not 100% O2 (i.e., is not 1 M) but only 21%, the value of the standard redox potential (Eo′) will not be equal +814 mV, but only +500 mV. Thus, aerobic conditions in the expression of redox potential, are in the range of Eo′ from +200 to +500 mV (points No. 12 and No. 11, respectively). Considering that R. solani AG 2-2IIIB has pH limitations, a suitable zone for its growth is limited by the points No. 5, 6, 9, 10. In other words, R. solani AG 2-2IIIB can grow only under aerobic conditions in the pH range varied between 4.0 and 8.0 and in the Eh range from +200 to +500 mV. Its existence outside of this specified zone is impossible. However, it should be taken into account that Rhizoctonia must be suppressed in soil ecosystems. Therefore, it is obvious that strong acidic, strong alkaline, and high potential conditions are not suitable, because they will lead to drastic changes in the soil microbiome. Consequently, we chose suppressive extreme factors that provide slightly alkaline, anoxygenic (absence of O2), and anaerobic (absence of O2 and Eh ≤ −200 mV) conditions. Such suppressive factors belong to physicochemical or biological categories. Physicochemical suppressive conditions can be created as follows. Slightly alkaline conditions can be created by phosphate buffers (mixture of Na2HPO4 and Na3PO4) and anoxygenic ones—due to the replacement of air with argon and anaerobic conditions—by the application of argon and low-potential reducing agents, such as Fe(II) citrate or Ti(III) citrate). Biological systems can simultaneously generate all three mentioned suppressive factors. The soil or compost microbiome is a good example. The natural microbiome is diversified and consists of aerobic, facultative, and obligate anaerobic microorganisms capable of fermenting a wide range of organic substrates. To see the effect, there is no need to identify the species content in microbial community. The conditions of the microbial community’s growth are of most interest. Clearly, when soil is flooded (a high layer of water) and some organic substrates (carbohydrates, proteins, etc.) are introduced into the soil, the overall microbial metabolism will shift towards anoxygenic and then deep anaerobic low-potential conditions. Thus, aerobic microorganisms will create anoxygenic conditions due to the consumption of O2, and then anaerobic microorganisms should create low-potential ones (Eh = −300… −200 mV) via the fermentation of organic compounds. During fermentation, due to the accumulation of alkaline end metabolites (S2−, NH3 etc.), an increase in pH is also expected. To verify the proposed approach, it is advisable, first of all, to test the effect of each physicochemical suppressive factor, and then their combined action on Rhizoctonia using a diversified microbiome. Finally, it is assumed that soil flooding and organic amendments are necessary and sufficient conditions for the strong suppression or death of Rhizoctonia solani AG 2-2IIIB.
Here, we highlighted the key conditions affecting the growth of R. solani AG 2-2IIIB. They are as follows: pH, Eh, and presence of O2. According to thermodynamic calculations, control of R. solani AG 2-2IIIB growth can be achieved via the creation of the described conditions. In this regard, two directions of the investigation were conducted. The first one created the specific growth conditions via the application of abiotic factors, namely pH and Eh buffers, oxygen absence, etc. Another pathway was to create such conditions via the application of microbial communities in order to regulate the pH, Eh, and O2 content of the medium caused by their growth.
3.2. Application of Abiotic Factors for Control of Rhizoctonia solani AG 2-2IIIB
3.2.1. Effect of pH on Rhizoctonia solani AG 2-2IIIB Growth
The response of R. solani AG 2-2IIIB depending on the pH of the culture medium was investigated. Peptone broth with yeast extract was used as the cultivation medium. The pH values (5.5; 7.0; 8.5) were maintained via the buffer solutions. The experiment resulted in the conclusion that alkaline conditions strongly suppressed the fungus growth (Figure 2). A visually detectable mycelium was observed only on the fourth day of cultivation. No changes were seen after 7 days of study. However, the alkaline conditions did not cause the death of the fungus. The recovery of mycelium growth was observed after the transfer of the agar block with mycelium onto nutrient agar on Petri plates. It evidenced that slightly alkaline conditions did not cause the devastation of R. solani AG 2-2IIIB.
Figure 2.
Effect of pH on Rhizoctonia solani AG 2-2IIIB growth: maintenance of pH = 5.5 (black line); maintenance of pH = 7.0 (red line); maintenance of pH = 8.5 (blue line); no pH maintenance (pink line).
Neutral and acidic conditions were suitable for the growth. Although the growth dynamics were similar, the increase in mycelium biomass was more intense at pH = 5.5. The lower growth efficiency compared to the control without pH regulation may have been caused by the higher ionic power of the solution with buffers. Thus, the thermodynamic calculations of the effect of pH on control of R. solani AG 2-2IIIB were confirmed. The conclusion that unfavorable pH conditions cause only growth inhibition without the death of mycelium was the key point of the study.
3.2.2. Effect of Eh and Presence of O2 on the Growth of Rhizoctonia solani AG 2-2IIIB
Aerobic conditions were shown to provide the effective growth of R. solani AG 2-2IIIB. Under such conditions, the growth of mycelium was active, resulting in a length of 29.3 ± 1.2 mm after 6 days of cultivation (Figure 3). The pH value ranged from 6.8 to 7.2. Eh slightly decreased from +255 mV to +238 mV. Thus, there was no inhibition of Rhizoctonia growth.
Figure 3.
Effect of Eh and presence of O2 on Rhizoctonia solani AG 2-2IIIB growth: aerobic conditions (black line); anoxygenic conditions (red line); anaerobic conditions (blue line).
The investigation of growth showed its inhibition under anoxygenic and anaerobic conditions. Very little mycelium growth under anoxygenic conditions was observed after only 6 days (1.7 ± 1.5 mm). The pH was similar under anoxygenic conditions and ranged from 6.7 to 7.1, but Eh reduced from +126 mV to +103 mV. Such conditions inhibited growth. Complete absence of mycelium growth came about under anaerobic conditions. In this case, the pH was 6.8–7.1. Eh remained at −200 ± 10 mV providing unfavorable conditions for R. solani AG 2-2IIIB. Thus, the presence of oxygen is necessary for R. solani AG 2-2IIIB growth. It provides high redox potential of the medium. Together, these factors maintained the metabolic activity of the fungus. The absence of oxygen and low redox potential did not support the growth of the fungus.
3.2.3. Recovery of Rhizoctonia solani AG 2-2IIIB Growth after Unfavorable Anoxygenic and Anaerobic Cultivation Conditions
Cultivation conditions affect the efficiency of growth. Aerobic conditions were shown to support the growth of R. solani AG 2-2IIIB. On the other hand, slight growth was observed in the case of anoxygenic conditions, and its absence was visualized in anaerobic ones. However, to test whether such conditions cause growth inhibition or death of R. solani AG 2-2IIIB, the inoculated agar blocks were transferred from anoxygenic and anaerobic conditions to the fresh peptone broth, and cultivation took place in aerobic conditions. Therefore, it was necessary to evaluate it after unfavorable growth conditions.
The following results were obtained. The recovery of the active fungus growth was predictable in aerobic conditions since the slight growth of mycelium was observed under anoxygenic ones. The length of mycelium was 6.7 ± 0.3 mm after one day of cultivation. One week of cultivation resulted in obtaining mycelium of 38.3 ± 2.1 mm in length. Thus, anoxygenic conditions can be concluded to cause only the suppression, but not the death of R. solani AG 2-2IIIB. After the resumption of optimal conditions, growth was recovered. However, the death of mycelium was evidenced in the case of pre-cultivation under anaerobic conditions. The recovery of growth was absent. Thus, creation of strict anaerobic low-potential conditions provided the death of fungal mycelium. Such an approach can be used to control its growth. Since the creation of such conditions via chemical and physical methods is complicated, microbiological methods are considered to be more promising.
3.3. Application of Biotic Factors for Control of Rhizoctonia solani AG 2-2IIIB
Alkaline pH, absence of O2, and low Eh created via abiotic factors are the key conditions shown to suppress R. solani AG 2-2IIIB. The application of microbial communities possessing a wide range of metabolic activity is also suitable as an effective tool to create such unfavorable conditions. Moreover, suppression can be enhanced due to the antagonistic properties of microbial exometabolites and even bacterial consumption of the dead mycelium as the nutrient source. In this regard, the application of microbial communities can provide effective control and irreversible suppression of R. solani AG 2-2IIIB. The co-cultivation of microbial communities from compost with R. solani AG 2-2IIIB revealed the following results (Figure 4). The control growth of R. solani did not significantly change pH (6.9–7.2) and Eh (+223…+257 mV). The length of mycelium reached 31 ± 0.5 mm after 7 days. However, the growth of microbial community affected the medium pH and Eh. No significant difference was observed between the growth of microbial community and its cultivation together with R. solani AG 2-2IIIB. The pH decreased from 7.2 to 6.1, and Eh dropped from +251 to −125 mV during 7 days.
Figure 4.
Dynamics of pH (a) and Eh (b) during the growth of R. solani AG 2-2IIIB and microbial community: separate cultivation of R. solani AG 2-2IIIB (black line); separate cultivation of microbiome (red line); co-cultivation of R. solani AG 2-2IIIB and microbiome (blue line).
Under these conditions, R. solani AG 2-2IIIB growth in the presence of microbial community was not observed. Since pH was favorable for R. solani AG 2-2IIIB, it was suggested that low redox potential and oxygen absence were the key conditions suppressing it. Moreover, the following transfer of the agar block, used as the inoculum of Rhizoctonia to peptone agar, confirmed complete death of mycelium during the cultivation with microbial community. Even one day of co-cultivation was enough to completely suppress R. solani AG 2-2IIIB. Therefore, a microbial community can be effectively used to control R. solani AG 2-2IIIB. This happens due to the consumption of oxygen, the creation of low redox potential (−150 mV and lower), and possibly production of antagonistic exometabolites during the growth of microbial community.
Similar patterns of R. solani AG 2-2IIIB growth interacting with the microbial community were confirmed during the cultivation on solid substrate (glass balls). Aerobic conditions allowed for the growth of mycelium, which reached 23 ± 2.1 mm length after 7 days. Anoxygenic and anaerobic conditions inhibited R. solani AG 2-2IIIB. The microbial community actively grew in all variants (aerobic, anoxygenic, and anaerobic). Moreover, after 1 day of cultivation, even in aerobic conditions, it reduced redox potential to −200 mV and lower, which was indicated by the discoloration of sodium rezasurin and BTB. Under such conditions R. solani AG 2-2IIIB growth in the presence of the microbial community was absent.
The following study of the opportunity to recover the growth of R. solani AG 2-2IIIB after 7 days of cultivation via its transfer to peptone agar was also confirmed. The mycelium started to grow on the second day after anoxygenic conditions. After anaerobic conditions, the growth recovery was absent. However, no growth of R. solani AG 2-2IIIB was observed after its joint cultivation with a microbial community under aerobic, anoxygenic, and anaerobic conditions. Therefore, microbial community plays a major role in not only inhibition, but also in the death of R. solani AG 2-2IIIB.
The unconditional role of the microbial community in the death of R. solani mycelium was also confirmed by the cultivation on its natural substrate (sugar beets) (Figure 5).
Figure 5.
Cultivation of R. solani AG 2-2IIIB on sugar beet slices: growth without microbial community (a); absence of growth with microbial community (b).
The sole cultivation of R. solani AG 2-2IIIB did not cause growth suppression. The green color of BTB indicated aerobic conditions and pH equal to 6.8–7.2. Under these conditions, the mycelium length reached 17.1 ± 1.3 mm. According to the yellow color of BTB, the growth of the microbial community provided acidification to pH = 5.0–6.0 during the first day of cultivation. The following BTB discoloration showed the creation of low redox potential (Eh ≤ −200 mV) in the liquid phase. Under such conditions, the absence of R. solani AG 2-2IIIB growth in the presence of the microbial community was predictable. The negative effect of the microbiome was so strong that, even after 10 days of cultivation, there was no growth of Rhizoctonia on the surface of sugar beet slices. The following transfer of agar blocks to peptone agar confirmed the R. solani AG 2-2IIIB growth absence, indicating the key role of the microbial community in the death of the fungus culture.
3.4. Antagonism of the Isolated Microbial Strains against Rhizoctonia solani AG 2-2IIIB
Since the microbial community was shown to be the best performing tool to control Rhizoctonia solani AG 2-2IIIB, the study of the antagonistic properties of its components was of great interest. For this, seven dominant strains were isolated. They showed different levels of inhibition of the growth of Rhizoctonia solani AG 2-2IIIB after 4 days of cultivation (Figure 6).
Figure 6.
Antagonistic activity of the isolated strains against R. solani AG 2-2IIIB: no growth suppression by the strain A.3 (a), growth suppression by the strain A.5 (b), and direct interaction of microorganisms and fungal mycelium — fungus and individual microorganism were inoculated at the same point (c).
Two methods of observing the antagonism showed similar results (Table 2). Both of them revealed that strains A.4, A.5, and A.7 most effectively suppressed mycelium growth. The first method, where R. solani AG 2-2IIIB was placed in the center of the nutrient agar in the Petri plate, was cultivated with the stripe of microbial culture. It revealed that some microbial metabolites of A.4 and A.5 strains could be responsible for the growth suppression. The strain A.7 probably synthesizes fewer inhibitory metabolites. However, direct contact also caused the suppression of R. solani AG 2-2IIIB. It is noteworthy that the A.4 strain turned out to be very active and not only inhibited the growth of mycelium, but also completely displaced the fungus (Figure 6c—the white colony, which completely overgrew R. solani inoculum).
Table 2.
Efficiency of suppression of Rhizoctonia solani AG 2-2IIIB by microbial strains.
No suppression of R. solani AG 2-2IIIB was shown by the strains A.1 and A.3 (Figure 6a). The strains A.2 and A.6 showed weak and middling effects, respectively. Though mycelium started to grow, direct contact with the microbial biomass suppressed the subsequent growth of the fungus. Thus, the investigation of the effect of the separate microbial strains on the growth of R. solani AG 2-2IIIB showed significant differences in the efficiency of the fungus suppression, as well as different pathways via direct contact or the synthesis of inhibitory metabolites. Further study of the best performing strains and the patterns of R. solani AG 2-2IIIB control is of great importance. It was assumed that the integration of the antagonistic properties of individual strains in the microbial community provided not only suppression of R. solani AG 2-2IIIB, but the death of the mycelium. Therefore, the further optimization of the regulation of microbial metabolism can become an effective tool to control the hazardous sugar beet pathogen R. solani AG 2-2IIIB in order to increase the yield of this valuable food plant, as well as to preserve it under storage.
4. Discussion
Sugar beet diseases caused by Rhizoctonia have been known for more than a century. However, despite many studies, the economic losses of the crop yield have reached up to 2% in the USA [32]. The loss of the production of sugar beets caused by Rhizoctonia solani AG 2-2 can reach, in some cases, more than 25% in the United States [33].
The conditions of R. solani growth have been studied since it was reported as the most widespread and hazardous crop pathogen. Attention to growth conditions has been primarily associated with the study of the pathways to suppress pathogens and prevent plant diseases [34]. Different approaches have been used to control this phytopathogenic fungus to protect sugar beets and increase its yield. The strategies were based on the development of resistant varieties of beets [33], application of fungicides [13], and treatment with bacterial strains [1] or some organic compounds [5]. However, these possess some drawbacks. For example, Rhizoctonia-resistant varieties lose 10–15% of their productivity [33], or they are not sufficiently adapted to the climate [6]. The application of chemicals causes the development of resistance to fungicides and leads to hazardous contamination of the environment [12].
Herein, a comprehensive approach based on thermodynamic calculations was suggested to evaluate a general view of the conditions that promote and suppress R. solani. This background was used to create conditions to control phytopathogenic R. solani. The approach suggested in the study to control R. solani AG 2-2IIIB via abiotic and biotic factors corresponds to the data in literature. However, the available data show that the investigation of growth conditions was conducted sporadically, without the use of a generalized background. The generalized patterns affecting R. solani AG 2-2IIIB were shown. Based on thermodynamic calculations, it was found that unfavorable growth conditions can be created via both pathways. The first one is the application of abiotic factors (pH and redox buffers, presence or absence of O2). The second pathway is to use biotic factors such as microbial communities to create the appropriate conditions not only to inhibit R. solani AG 2-2IIIB growth, but also to cause the death of mycelium.
The value of pH is one of the important factors affecting the activity of Rhizoctonia and pathogenicity [35,36]. A wide variation of pH (6.0–8.0) was shown for optimum growth and sclerotia production [36]. Other reported data revealed the optimum growth of fungus in the pH range 5.5–7.0 [35]. The absence of oxygen, together with low redox potential, is another important condition to suppress R. solani. Anaerobic soil disinfestation implemented via the addition of easily degradable organics with water was shown to be effective in the control of a wide range of plant pathogens, including R. solani [37].
The application of microorganisms, conducted in our research, was shown to be an effective and up-to-date approach to control R. solani AG 2-2IIIB. It is one of the most promising ways to provide the suppression of the fungus as well as to prevent environmental pollution. Moreover, some microbial strains such as Bacillus sp. [33] and yeasts (Candida valida, Rhodotorula glutinis, and Trichosporon asahii) [38] described in literature were shown not only to suppress Rhizoctonia solani, but also to increase the yield of sugar beets. Bacillus amyloliquefaciens SB14 strain was shown to decrease diseases of sugar beet caused by R. solani AG-4 and R. solani AG 2-2 [9,39]. Other bacterial strains such as Serratia plymuthica 3Re4-18, Pseudomonas fluorescens L13-6-12, and Pseudomonas trivialis RE*1-1-14, and fungal species (Trichoderma gamsii AT1-2-4, Trichoderma velutinum G1/8) were also shown to be promising to control Rhizoctonia solani [40]. The antagonistic mechanisms can be different: competition for substrate and space, production of inhibitory metabolites, cell wall degrading enzymes, etc. [38,41].
The conducted research confirmed that microorganisms were able to inhibit or even kill R. solani AG 2-2IIIB. The study showed that the creation of anaerobic conditions (absence of air and low redox potential) by the microbial community of compost was the most effective to control R. solani AG 2-2IIIB. The investigation of the antagonistic properties of the isolated microbial strains was also shown to affect the fungus. The collected data confirmed that the application of microbial communities was the most promising approach. It provided the integration of the suppressive environmental conditions created by microorganisms with the antagonistic properties of the strains. These experimental data correspond to those described in literature, such as the synergistic effect of the combination of several strains such as Gliocladium virens and Burkholderia cepacia [38,42]. Another study also confirmed the increase in the antagonistic effect of combining several microbial strains. Moreover, microorganisms could contribute to plant health via the stimulation of root growth, germination rates, biomass yield, resistance to stress, etc. [40].
Although the approach of Rhizoctonia solani control via the application of microorganisms is promising, there are still a lot of gaps in the knowledge of the effective regulation of this process. The conducted research contributed to the understanding of the patterns of the application of microbial communities instead of single strains. Microbial communities were shown to be a promising tool, since they possess integrated mechanisms against R. solani AG 2-2IIIB, providing the simultaneously acting different pathways to protect a valuable food source: sugar beets.
5. Conclusions
The application of thermodynamic prediction provided the background for studying the conditions for Rhizoctonia solani AG 2-2IIIB control. Obtained data showed the following. The abiotic factors provided via the chemical buffers or removal of oxygen mainly caused the inhibition of R. solani. The values of 5.5 ≤ pH ≤ 8.5, Eh ≤ −200 mV, and oxygen absence inhibited its growth. The maintenance of these factors via microbial communities enhanced the suppressive effect, which provided the death of mycelium. The study of microbial strains revealed the inhibitory effect of microbial metabolites and provided more effective control of Rhizoctonia solani AG 2-2IIIB. Agreeing with the thermodynamic prediction, the main negative factors inhibiting R. solani AG 2-2IIIB growth are anaerobic conditions and a diversified microbial community. The simultaneous combination of these factors leads to the suppression of metabolism and death of R. solani AG 2-2IIIB. The proposed approach is promising for further development, since it provides environmentally friendly control of phytopathogenic fungi to prevent the disease of sugar beets: a valuable food crop.
Author Contributions
Conceptualization, V.H. and E.M.; methodology, O.T. and A.K.; software, V.H.; validation, V.H., O.T., A.K. and E.M.; formal analysis, V.H. and A.K.; investigation, V.H. and O.T.; resources, E.M.; data curation, V.H., A.K. and O.T.; writing—original draft preparation, V.H., O.T., A.K. and E.M.; writing—review and editing, V.H., O.T., A.K. and E.M.; visualization, V.H.; supervision, E.M.; project administration, E.M.; funding acquisition, V.H. All authors have read and agreed to the published version of the manuscript.
Funding
This research was funded by National Science Center (Poland), grant number UOM-2022/01/3/NZ9/00101.
Institutional Review Board Statement
Not applicable.
Informed Consent Statement
Not applicable.
Data Availability Statement
The data presented in this study are available on request from the corresponding author.
Conflicts of Interest
The authors declare no conflict of interest.
References
- Kumar, A.; Kumar, S.P.J.; Chintagunta, A.D.; Agarwal, D.K.; Pal, G.; Singh, A.N.; Simal-Gandara, J. Biocontrol Potential of Pseudomonas stutzeri Endophyte from Withania somnifera (Ashwagandha) Seed Extract against Pathogenic Fusarium oxysporum and Rhizoctonia solani. Arch. Phytopathol. Plant Prot. 2022, 55, 1–18. [Google Scholar] [CrossRef]
- Luo, G.; Karakashev, D.; Xie, L.; Zhou, Q.; Angelidaki, I. Long-Term Effect of Inoculum Pretreatment on Fermentative Hydrogen Production by Repeated Batch Cultivations: Homoacetogenesis and Methanogenesis as Competitors to Hydrogen Production. Biotechnol. Bioeng. 2011, 108, 1816–1827. [Google Scholar] [CrossRef] [PubMed]
- Yang, Q.; Yang, L.; Wang, Y.; Chen, Y.; Hu, K.; Yang, W.; Zuo, S.; Xu, J.; Kang, Z.; Xiao, X.; et al. A High-Quality Genome of Rhizoctonia solani, a Devastating Fungal Pathogen with a Wide Host Range. Mol. Plant-Microbe Interact. 2022, 35, 954–958. [Google Scholar] [CrossRef] [PubMed]
- Majumdar, R.; Strausbaugh, C.A.; Galewski, P.J.; Minocha, R.; Rogers, C.W. Cell-Wall-Degrading Enzymes-Related Genes Originating from Rhizoctonia solani Increase Sugar Beet Root Damage in the Presence of Leuconostoc mesenteroides. Int. J. Mol. Sci. 2022, 23, 1366. [Google Scholar] [CrossRef] [PubMed]
- González-Hernández, A.I.; Pérez-Sánchez, R.; Plaza, J.; Morales-Corts, M.R. Compost Tea as a Sustainable Alternative to Promote Plant Growth and Resistance against Rhizoctonia solani in Potato Plants. Sci. Hortic. 2022, 300, 111090–111099. [Google Scholar] [CrossRef]
- Büttner, G.; Pfähler, B.; Märländer, B. Greenhouse and Field Techniques for Testing Sugar Beet for Resistance to Rhizoctonia Root and Crown Rot. Plant Breed. 2004, 123, 158–166. [Google Scholar] [CrossRef]
- Barreto, A.; Paulus, S.; Varrelmann, M.; Mahlein, A.-K. Hyperspectral Imaging of Symptoms Induced by Rhizoctonia solani in Sugar Beet: Comparison of Input Data and Different Machine Learning Algorithms. J. Plant Dis. Prot. 2020, 127, 441–451. [Google Scholar] [CrossRef]
- Postma, J.; Schilder, M.T. Enhancement of Soil Suppressiveness against Rhizoctonia solani in Sugar Beet by Organic Amendments. Appl. Soil Ecol. 2015, 94, 72–79. [Google Scholar] [CrossRef]
- Me, H.; Ms, P. Sugar Beet, It ‘disease Rhizoctonia Root Rot, and Potential Biological Agents. Agric. Biol. Res. 2021, 37, 96–101. [Google Scholar]
- Ravi, S.; Hassani, M.; Heidari, B.; Deb, S.; Orsini, E.; Li, J.; Richards, C.M.; Panella, L.W.; Srinivasan, S.; Campagna, G.; et al. Development of an SNP Assay for Marker-Assisted Selection of Soil-Borne Rhizoctonia solani AG-2-2-IIIB Resistance in Sugar Beet. Biology 2022, 11, 49. [Google Scholar] [CrossRef]
- Hassani, M.; Heidari, B.; Mahmoudi, S.B.; Taleghani, D.F.; Stevanato, P. Identification of Owen-Type Male Sterility Maintainers Carrying Resistance Against Rhizoctonia Crown and Root Rot (Rcrr) Disease in Sugar Beet Germplasm. Sugar Tech 2019, 21, 959–965. [Google Scholar] [CrossRef]
- Akhter, W.; Bhuiyan, M.K.A.; Sultana, F.; Hossain, M.M. Integrated Effect of Microbial Antagonist, Organic Amendment and Fungicide in Controlling Seedling Mortality (Rhizoctonia solani) and Improving Yield in Pea (Pisum sativum L.). C. R. Biol. 2015, 338, 21–28. [Google Scholar] [CrossRef]
- Al-Baldawy, M.S.M.; Matloob, A.A.A.H.; Almammory, M.K.N. Effect of Plant Extracts and Biological Control Agents on Rhizoctonia solani Kuhn. IOP Conf. Ser. Earth Environ. Sci. 2021, 735, 012079–012087. [Google Scholar] [CrossRef]
- Díaz-Díaz, M.; Bernal-Cabrera, A.; Trapero, A.; Medina-Marrero, R.; Sifontes-Rodríguez, S.; Cupull-Santana, R.D.; García-Bernal, M.; Agustí-Brisach, C. Characterization of Actinobacterial Strains as Potential Biocontrol Agents against Macrophomina phaseolina and Rhizoctonia solani, the Main Soil-Borne Pathogens of Phaseolus Vulgaris in Cuba. Plants 2022, 11, 645. [Google Scholar] [CrossRef]
- Bonanomi, G.; Zotti, M.; Idbella, M.; Cesarano, G.; Al-Rowaily, S.L.; Abd-ElGawad, A.M. Mixtures of Organic Amendments and Biochar Promote Beneficial Soil Microbiota and Affect Fusarium oxysporum f. sp. Lactucae, Rhizoctonia solani and Sclerotinia minor Disease Suppression. Plant Pathol. 2022, 71, 818–829. [Google Scholar] [CrossRef]
- Tashyrev, O.; Hovorukha, V.; Havryliuk, O.; Sioma, I.; Gladka, G.; Kalinichenko, O.; Włodarczyk, P.; Suszanowicz, D.; Zhuk, H.; Ivanov, Y. Spatial Succession for Degradation of Solid Multicomponent Food Waste and Purification of Toxic Leachate with the Obtaining of Biohydrogen and Biomethane. Energies 2022, 15, 911. [Google Scholar] [CrossRef]
- Kucharska, K.; Katulski, B.; Goriewa, K.; Duba, A.; Wachowska, U. Pathogenicity and Fungicide Sensitivity of Rhizoctonia solani and R. cerealis Isolates. Gesunde Pflanz. 2018, 70, 13–19. [Google Scholar] [CrossRef]
- Moliszewska, E.B.; Schneider, J.H.M. Some Pathogenic Properties of Rhizoctonia solani to Sugar Beet Seedlings. Plant Prot. Sci. 2002, 38, 322–324. [Google Scholar] [CrossRef]
- Bolton, M.D.; Panella, L.; Campbell, L.; Khan, M.F.R. Temperature, Moisture, and Fungicide Effects in Managing Rhizoctonia Root and Crown Rot of Sugar Beet. Phytopathology 2010, 100, 689–697. [Google Scholar] [CrossRef]
- Moliszewska, E.; Nabrdalik, M.; Ziembik, Z. Rhizoctonia solani AG 11 Isolated for the First Time from Sugar Beet in Poland. Saudi J. Biol. Sci. 2020, 27, 1863–1870. [Google Scholar] [CrossRef]
- Nabrdalik, M.; Moliszewska, E.; Wierzba, S. Importance of Endophytic Strains Pantoea agglomerans in the Biological Control of Rhizoctonia solani. Ecol. Chem. Eng. S 2018, 25, 331–342. [Google Scholar] [CrossRef]
- Jacobsen, B.J. Root Rot Diseases of Sugar Beet. Zb. Matice Srp. Za Prir. Nauk. 2006, 110, 9–19. [Google Scholar]
- Bartholomäus, A.; Mittler, S.; Märländer, B.; Varrelmann, M. Control of Rhizoctonia solani in Sugar Beet and Effect of Fungicide Application and Plant Cultivar on Inoculum Potential in the Soil. Plant Dis. 2017, 101, 941–947. [Google Scholar] [CrossRef]
- Ayala, G.; Buettner, G.; Guitierrez, H.; Heijbroek, W.; Ioannides, P.; Nihlgaard, M.; Molard, R.; Panella, L.; Rossi, V.; Roesner, H.; et al. Integrated Control of Rhizoctonia Root Rot. First Results of an International Institute for Beet Research Trial Series. In Proceedings of the Comptes-Rendus des Congres de l’Institut International de Recherches Betteravieres, Belgium, 2001; Available online: https://scholar.google.com/scholar_lookup?title=Integrated+control+of+rhizoctonia+root+rot.+First+results+of+an+International+institute+for+beet+research+trial+series&author=Ayala%2C+G.&publication_year=2001 (accessed on 22 May 2023).
- Moliszewska, E.B. Etiologia Wybranych Chorób Korzeni Buraka Cukrowego; Wydawnictwo Uniwersytetu Opolskiego: Opole, Poland, 2009. [Google Scholar]
- Pourbaix, M. Thermodynamics of Dilute Aqueous Solutions: Graphical Representation of the Role of pH and Potential. Ph.D. Thesis, Delft Institute of Technology, Delft, The Netherlands, 1945. [Google Scholar]
- Pourbaix, M. Atlas of Electrochemical Equilibria in Aqueous Solution. NACE 1974, 648. [Google Scholar]
- Hovorukha, V.; Havryliuk, O.; Gladka, G.; Tashyrev, O.; Kalinichenko, A.; Sporek, M.; Dołhańczuk-Śródka, A. Hydrogen Dark Fermentation for Degradation of Solid and Liquid Food Waste. Energies 2021, 14, 1831. [Google Scholar] [CrossRef]
- Palaniveloo, K.; Amran, M.A.; Norhashim, N.A.; Mohamad-Fauzi, N.; Peng-Hui, F.; Hui-Wen, L.; Kai-Lin, Y.; Jiale, L.; Chian-Yee, M.G.; Jing-Yi, L.; et al. Food Waste Composting and Microbial Community Structure Profiling. Processes 2020, 8, 723. [Google Scholar] [CrossRef]
- Nikolsky, B.P. Chemistry Handbook, Chemical Equilibrium and Kinetics. Properties of Solutions. In Electrode Processes; Chemistry: Leningrad, Russia, 1965; Volume 3, p. 1008. [Google Scholar]
- Lehninger, A.; Nelson, D.; Cox, M. Principles of Biochemistry, 2nd ed.; Worth: New York, NY, USA, 1993; p. 1090. [Google Scholar]
- Herr, L.J. Sugar Beet Diseases Incited by Rhizoctonia spp. In Rhizoctonia Species: Taxonomy, Molecular Biology, Ecology, Pathology and Disease Control; Sneh, B., Jabaji-Hare, S., Neate, S., Dijst, G., Eds.; Springer: Dordrecht, The Netherlands, 1996; pp. 341–349. ISBN 978-94-017-2901-7. [Google Scholar]
- Kiewnick, S.; Jacobsen, B.J.; Braun-Kiewnick, A.; Eckhoff, J.L.A.; Bergman, J.W. Integrated Control of Rhizoctonia Crown and Root Rot of Sugar Beet with Fungicides and Antagonistic Bacteria. Plant Dis. 2001, 85, 718–722. [Google Scholar] [CrossRef]
- Ritchie, F.; Bain, R.A.; McQuilken, M.P. Effects of Nutrient Status, Temperature and pH on Mycelial Growth, Sclerotial Production and Germination of Rhizoctonia solani from Potato. J. Plant Pathol. 2009, 91, 589–596. [Google Scholar]
- Nuri, T.; Biswas, M.K. Impact of Different Culture Media, Temperature and pH on Growth of Rhizoctonia solani i Kühn Causes Black Scurf of Potato. Plant Cell Biotechnol. Mol. Biol. 2021, 22, 27–33. [Google Scholar]
- Goswami, B.K.; Rahaman, M.M.; Hoque, A.; Bhuiyan, K.; Mian, I.H. Variations In Different Isolates Of Rhizoctonia solani Based On Temperature And pH. Bangladesh J. Agric. Res. 2011, 36, 389–396. [Google Scholar] [CrossRef]
- Hewavitharana, S.S.; Mazzola, M. Carbon Source-Dependent Effects of Anaerobic Soil Disinfestation on Soil Microbiome and Suppression of Rhizoctonia solani AG-5 and Pratylenchus penetrans. Phytopathology 2016, 106, 1015–1028. [Google Scholar] [CrossRef]
- El-Tarabily, K.A. Suppression of Rhizoctonia solani Diseases of Sugar Beet by Antagonistic and Plant Growth-promoting Yeasts. J. Appl. Microbiol. 2004, 96, 69–75. [Google Scholar] [CrossRef]
- Karimi, E.; Safaie, N.; Shams-Baksh, M.; Mahmoudi, B. Bacillus amyloliquefaciens SB14 from Rhizosphere Alleviates Rhizoctonia Damping-off Disease on Sugar Beet. Microbiol. Res. 2016, 192, 221–230. [Google Scholar] [CrossRef]
- Zachow, C.; Fatehi, J.; Cardinale, M.; Tilcher, R.; Berg, G. Strain-Specific Colonization Pattern of Rhizoctonia Antagonists in the Root System of Sugar Beet. FEMS Microbiol. Ecol. 2010, 74, 124–135. [Google Scholar] [CrossRef]
- Masih, E.I.; Paul, B. Secretion of β-1,3-Glucanases by the Yeast Pichia membranifaciens s and Its Possible Role in the Biocontrol of Botrytis cinerea Causing Grey Mold Disease of the Grapevine. Curr. Microbiol. 2002, 44, 391–395. [Google Scholar] [CrossRef]
- Mao, W.; Lewis, J.A.; Lumsden, R.D.; Hebbar, K.P. Biocontrol of Selected Soilborne Diseases of Tomato and Pepper Plants. Crop Prot. 1998, 17, 535–542. [Google Scholar] [CrossRef]
Disclaimer/Publisher’s Note: The statements, opinions and data contained in all publications are solely those of the individual author(s) and contributor(s) and not of MDPI and/or the editor(s). MDPI and/or the editor(s) disclaim responsibility for any injury to people or property resulting from any ideas, methods, instructions or products referred to in the content. |
© 2023 by the authors. Licensee MDPI, Basel, Switzerland. This article is an open access article distributed under the terms and conditions of the Creative Commons Attribution (CC BY) license (https://creativecommons.org/licenses/by/4.0/).